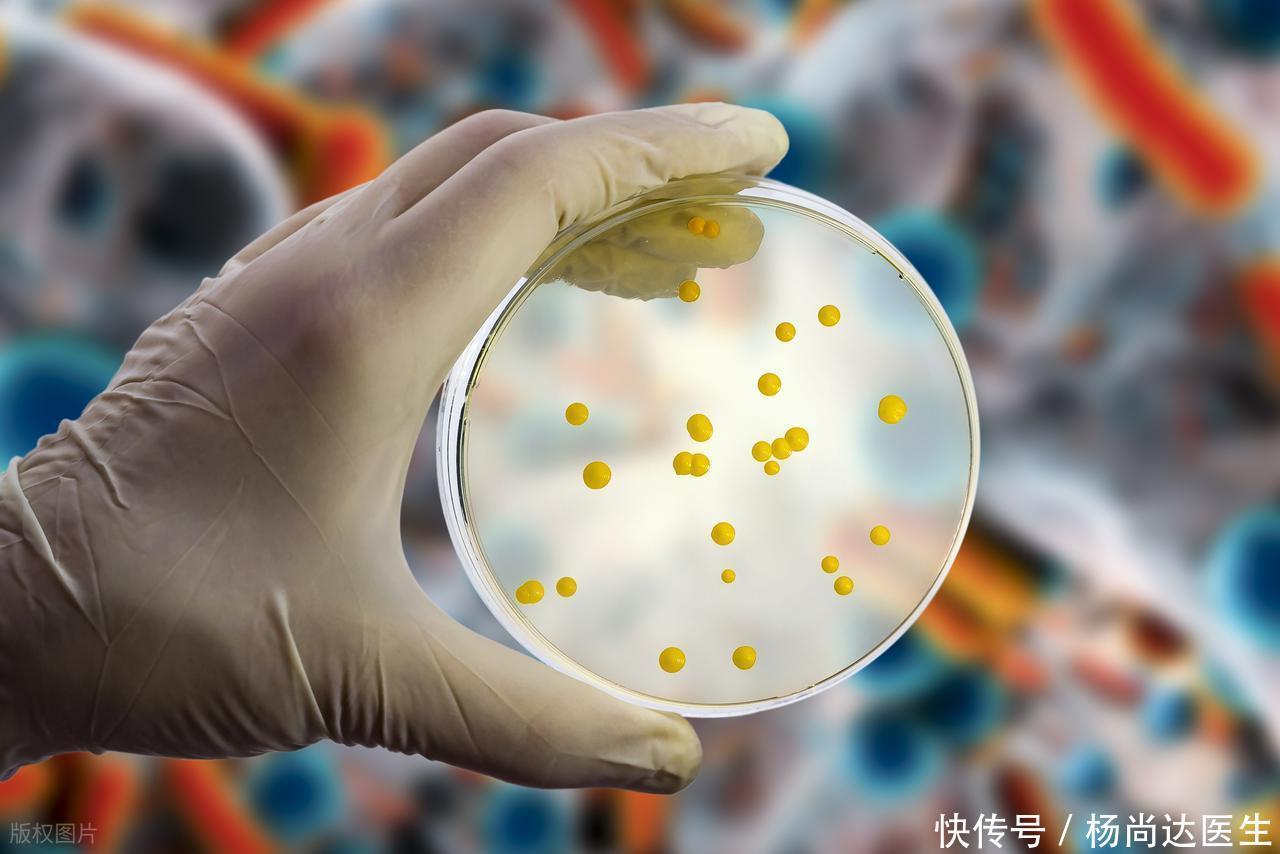

许多人反复出现腹胀、放屁多、饭后不适或间断腹泻,常被各种“肠道问题”说得头晕。就算做了常规检查,结果也可能莫名正常,这让人怀疑自己的症状被忽视。小肠细菌过度生长(SIBO)被一些媒体称为肠道的“刺客”,让患者既恐慌又渴望实用建议:到底哪些食物该少吃?怎样检测才可靠?如何在日常生活中真正保护肠道而不被误导?

什么是小肠细菌过度生长,它真的是“刺客”吗?当小肠内细菌数量或种类异常增多,就可能干扰消化吸收。细菌发酵碳水会产生气体,胀气与排气增多由此而来;某些菌群分解维生素或与黏膜相互作用,长期则可能造成营养吸收减少或慢性炎性刺激。因此它并非立刻致命的“刺客”,但在存在肠蠕动减慢、结构异常或长期用药等诱因时,病情更容易反复并影响生活质量。临床上,呼气氢/甲烷试验与取材培养各有局限,诊断需要结合症状与风险因素判断。
想护肠,为什么要少吃这两类食物?第一类是富含可发酵碳水的食物(如部分水果、乳糖及一些蔬菜中高FODMAP成分)。这些碳水在小肠被细菌迅速发酵,导致气体和渗透性改变,短期内会加重胀气与腹泻。第二类是高脂或高度加工的食品,它们一方面延缓胃肠推进,容易造成内容物停留,给细菌繁殖创造条件;另一方面常伴大量添加糖、糖醇或防腐剂,可能改变菌群平衡。并非要求彻底避免,而是建议在症状明显时限制摄入频率与份量,观察症状随食物变化的反应。

怎样检测或确认小肠细菌过度生长?常用的非侵入性方法为呼气试验,通过口服特定糖类后监测氢或甲烷峰值来提示过度发酵;优点是简单,缺点是假阳性或假阴性都可能出现,尤其当肠道通过速度异常时。小肠取液培养被视为更直接的证据,但流程复杂且并非每位患者都适合。临床上建议在识别诱因、评估症状严重度后与医生讨论合适的检测策略,并把检测结果放在整体临床背景下解读,而不是孤立断言。

除了改变饮食,还能做什么保护肠道?可以先从改善肠道动力与去除可逆诱因着手:适当分餐、规律进食、减少长期使用抑酸药或麻醉性止痛剂(在医生指导下调整),这些做法有助于缩短细菌滞留时间。必要时,针对性抗菌治疗或短期促动力药物可由医生评估使用;益生菌的效果因菌株而异,应结合症状选择并观察疗效。定期随访并在症状缓解后逐步恢复均衡饮食,比长期严格限制更利于营养与生活质量。

面对“刺客”式的恐惧,不如把注意力放回可控事项:识别可改善的诱因、在医生指导下选择检测和治疗、在症状高峰期适当限制两类食物并记录反应。大多数人通过综合管理能显著减轻不适。若你有持续或加重的症状,请及时就医,早期评估会让后续调整更有针对性。
万生优配提示:文章来自网络,不代表本站观点。